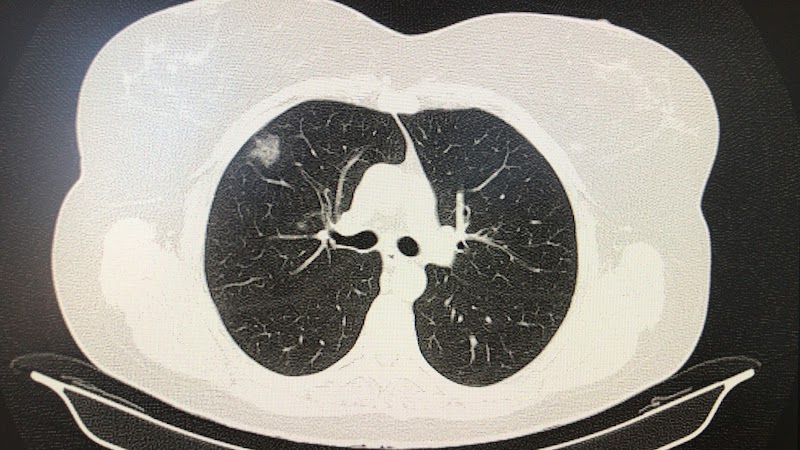
Imagen de Clinica Dr. German Saez Roca, Neumologo-apnea del Sueño-asma Grave

Ubicación
Cerca de Ronda (Granada)
Opiniones en Google Maps
El doctor D. German es un gran profesional por no decir el mejor de todos los que he conocido. Además de una gran persona amable, empática, comprensiva y que se ha preocupado desde el minuto uno por escucharme y atenderme de la manera mas atenta y cercana posible. En todo momento se preocupa por tu salud. Lo recomiendo totalmente
Tuve una cita hace poco con el Dr Germán y el trató fue inmejorable, valoró todo los síntomas y llego a una conclusión con las pruebas que el realizó, me dio tranquilidad ya que estaba agobiado por los síntomas. Sin duda un buen doctor
Es un gran médico desde el punto de vista profesional. Atento y comprensivo como persona. Muestra un gran interesa por el paciente. En su consulta te sientes en muy buenas manos y percibes su preocupación por tu estado.
Mi experiencia con el Dr. Sáez ha sido excepcional. Desde el primer momento, su profesionalismo y manera correcta de actuar me brindaron una gran seguridad, haciéndome sentir en manos expertas. Su forma de comunicarse es tranquila y reflexiva, lo que facilita una interacción muy agradable. Se tomó el tiempo necesario para realizar un diagnóstico completo, abordando mi situación con todas las pruebas necesarias. Afortunadamente, el tratamiento que me prescribió está surtiendo un efecto positivo en mi salud. Es evidente que el Dr. Sáez ama su profesión y esto se refleja en la calidad de su trabajo. Recomiendo altamente sus servicios a cualquiera que busque un especialista comprometido y eficaz.
Gracias a Dios todavía existen médicos como el Dr. Sáez. Ha conseguido resolver en tan sólo dos semanas un problema de salud que llevaba arrastrando más de 30 años y que estaba limitando bastante mi calidad de vida. Acertó a la primera con el diagnóstico y con el tratamiento adecuado, lo que demuestra su gran experiencia ya que mi caso no era nada fácil. No tengo suficientes palabras de agradecimiento con las que expresarle mi gratitud por su gran profesionalidad, amabilidad, trato, dedicación y buen hacer. Es un gran médico y una excelente persona que me ha devuelto la salud. Le estaré eternamente agradecido